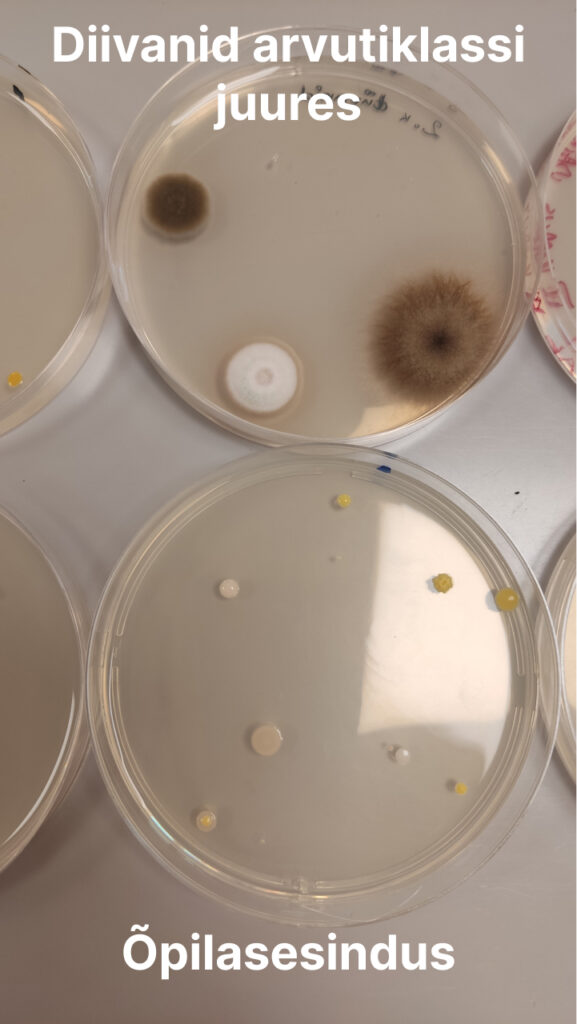

Bioloogia tunnis tehti rakkude paljunemise ja paljunemiskiiruse arvutamise raames eksperimente: millised bakterid jt mikroobid meie kehal elavad ning meie kooli ruumides lenduvad?
Selleks tehti kõigepealt nn mikrobioloogiline sõrmejälg ehk sõrmekülv – õpilased puudutasid sõrmega söötmetassi pinda. Söötmetassil on vajalikud toitained bakterite kiireks kasvamiseks ning sellel hakkavad sinu nahalt söötmetassile sattunud bakterid (ja teised mikroobid) paljunema. Palju aitab ka kaasa, kui klassis on 27 °C… Nii võib ööpäevaga saada ühest bakterist miljardeid baktereid ja võib tekkida silmale nähtav koloonia ehk pesa.
Vaata pilte ning arva: milliseid sektoreid puudutasid õpilased nn musta sõrmega, milliseid desinfitseeritud sõrmega? Kas on erinevust näha? “Musta sõrme” alla loeti sõrm, mis on pesemata/desinfitseerimata või millega õpilane puudutas nt telefoniekraani – kõige räpasemat vahendit inimese arsenalis.
Teisena uuriti erinevates kooli ruumides lenduvaid mikroobe. Selleks lasti söötmetassidel olla avatud 10 minutit erinevates ruumides. Tehti ka hääletus: milline ruum valitute hulgast on arvatavasti kõige “räpasem” (kus leidub kõige enam mikroobe)?! Arusaadavalt sai 57% häältest poiste riietusruum… kuidas olid aga lood tegelikult?
Üks stereotüüp pidas paika: poiste riietusruumis viibinud söötmetassil kasvas 6 bakterikolooniat, tüdrukute omal 2… Aga kui sa arvad, et poiste riietusruum oli kõige räpasem koht meie koolimajas, siis sa eksid! Selleks kujunes valitute hulgast II korruse idatiiva WC (paremat kätt esimene), mille õhkkülvil esines üle 30 bakterikoloonia. Ning I korruse WC-s (admini juures) viibinud söötmetassil kasvas koletislik hallitusseen, mis terve söötmetassi (kaasa arvatud selle alla jäänud teised hallitused) enda alla mattis. Ka armastavad arvutiklassi juures olevat diivanit lisaks õpilastele vähemalt kolm hallitusseene liiki: must kerahallik, tõenäoliselt üks teine kerahalliku liik ja üks tuvastamata hallitusseene liik.
Tundub aga, et direktorit kardavad ühtemoodi nii õpilased kui bakterid, sest direktori kabinetis viibinud söötmetassil ei ilmunud mitte ühtki kolooniat…